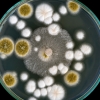
지구를 구할 ‘플라스틱 먹는 곰팡이’ 연구 시작

-
아동 동의 없이 개인정보 수집 논란… 안심귀가 서비스 신고 방식 복잡
2018-10-10 서울Pn -

“풍계리 사찰로 核수준 확인… 핵실험 안 한 3·4번 갱도 검증해야”
2018-10-10 서울신문 -
[사설] 日 후쿠시마 원전 오염수 방출, 주변국과 협의해야
2018-10-09 서울신문 -

강용석 “북한산 송이 방사능 검사는 하고 먹는 건가”
2018-09-23 서울신문 -
대법 “환경오염 원인 최초 제공자도 손해 배상해야”
2018-09-23 서울신문 -
[인사]
2018-09-18 서울신문 -

이효열 작가 “순직한 집배원에게 국화꽃 한 송이 부칩니다”
2018-09-17 서울신문 -
지구를 구할 ‘플라스틱 먹는 곰팡이’ 연구 시작
2018-09-13 나우뉴스 -

올리비아 뉴턴 존 세 번째 유방암 “마리화나로 이겨내고 있다”
2018-09-11 서울신문 -
의정부시, 경기도식품안전관리평가에서 ‘최우수’
2018-09-07 서울신문 -

성남시 라돈 측정기 50대 추가 구매... 104대 시민에 대여
2018-09-05 서울Pn -
![[단독] 단톡방서 “돌격 앞으로” 작전명령… 전투방식 혁명적 변화 예고](https://img.seoul.co.kr/img/upload/2018/09/03/SSI_20180903222105_S.jpg)
[단독] 단톡방서 “돌격 앞으로” 작전명령… 전투방식 혁명적 변화 예고
2018-09-04 서울신문 -

美넷플릭스, ‘日후쿠시마 원전’ 과장·희화화 논란
2018-09-02 서울신문 -
![[명경재의 DNA세계] 태양을 피해야 하는 이유](https://img.seoul.co.kr/img/upload/2018/08/27/SSI_20180827172110_S.jpg)
[명경재의 DNA세계] 태양을 피해야 하는 이유
2018-08-28 서울신문 -
부산대에 원전 해체 전문인력 양성과정 개설..5년간 100명 원전 해체 전문인력양성
2018-08-23 서울신문 -
![[기고] 에너지 전환이 발전사업 적자의 주범?/임성진 에너지전환포럼 공동대표](https://img.seoul.co.kr/img/upload/2018/08/20/SSI_20180820172152_S.jpg)
[기고] 에너지 전환이 발전사업 적자의 주범?/임성진 에너지전환포럼 공동대표
2018-08-21 서울신문 -
日 후쿠시마 ‘방호복 소년’ 동상… 주민 반대로 된서리
2018-08-14 서울신문 -
![[글로벌 인사이트] 쉽고 값싼 ‘살인 드론’… 전 세계로 공포 배달](https://img.seoul.co.kr/img/upload/2018/08/13/SSI_20180813175745_S.jpg)
[글로벌 인사이트] 쉽고 값싼 ‘살인 드론’… 전 세계로 공포 배달
2018-08-14 서울신문 -
![[열린세상] ‘지구를 불태우는’ 폭염과 인류세/하대청 광주과학기술원 기초교육학부 교수](https://img.seoul.co.kr/img/upload/2018/08/05/SSI_20180805184335_S.jpg)
[열린세상] ‘지구를 불태우는’ 폭염과 인류세/하대청 광주과학기술원 기초교육학부 교수
2018-08-06 서울신문 -
![[아하! 우주] 누구있나요?…NASA 행성사냥꾼 ‘TESS’ 탐사 시작](https://imgnn.seoul.co.kr/img/upload/2018/07/30/SSI_20180730154848_S.jpg)
[아하! 우주] 누구있나요?…NASA 행성사냥꾼 ‘TESS’ 탐사 시작
2018-07-30 나우뉴스 -
‘매일 사우나’ 도쿄… 올림픽은요?
2018-07-26 서울신문 -

‘이렇게 더우면 도쿄올림픽 어떻게 치르지’ 조직위의 답은
2018-07-25 서울신문 -

동계올림픽도 女風당당… 메달 밭 커진다
2018-07-20 서울신문 -

CT, MRI에 쓰이는 방사성동위원소 국내 생산 눈 앞
2018-07-19 서울신문 -

NASA 새 ‘행성 사냥꾼’ TESS, 이달 안에 탐사 시작한다
2018-07-16 나우뉴스 -

젖고 이끼 낀 ‘라돈 침대’ 더미… “꺼림칙한데 관광객이 오겄슈”
2018-07-16 서울신문 -
유방암 진단과 치료효과 예측 가능한 의약품 개발
2018-06-28 서울신문 -
유방암 진단과 치료효과 예측 가능한 의약품 개발
2018-06-28 서울신문 -

악성 유방암 진단과 치료기간 한 번에 예측한다
2018-06-28 서울신문 -
당진 ‘라돈침대’ 내일부터 대진 천안공장으로
2018-06-25 서울신문

